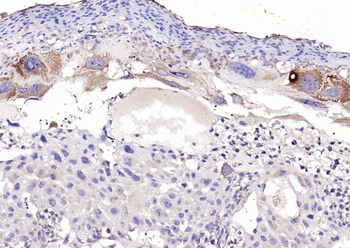
Phospho-PERK (Thr982) Rabbit Polyclonal Antibody
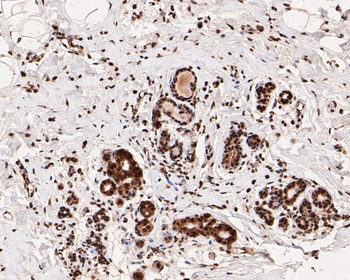
Phospho-Estrogen Receptor alpha (Ser118) Recombinant Rabbit Monoclonal Antibody

You have no items in your shopping cart.
- Featured

FC, IF, IHC
Human, Mouse, Rat
Bovine, Canine, Equine, Gallus, Guinea pig, Porcine, Rabbit
Rabbit
Polyclonal
Unconjugated
50 μl, 100 μl, 200 μl - Featured

IF, IHC-Fr, IHC-P
Human, Mouse, Rat
Bovine, Canine, Porcine
Rabbit
Polyclonal
Unconjugated
200 μl, 50 μl, 100 μl - CD38 Recombinant Rabbit Monoclonal Antibody [orb704512]Featured

FC, ICC, IF, IHC-Fr, IHC-P, WB
Human
Rabbit
Recombinant
Unconjugated
25 μl, 100 μl, 50 μl - Phospho-PERK (Thr982) Rabbit Polyclonal Antibody [orb500026]Featured

FC, ICC, IF, IHC-Fr, IHC-P
Human, Mouse, Rat
Rabbit
Rabbit
Polyclonal
Unconjugated
50 μl, 200 μl, 100 μl - Featured

ELISA, FC, IF, IHC-Fr, IHC-P, WB
Human, Mouse, Rabbit, Rat
Bovine, Canine, Gallus, Porcine
Rabbit
Polyclonal
Unconjugated
100 μl, 50 μl, 200 μl - Featured

ELISA, FC, ICC, IF, IHC-Fr, IHC-P, WB
Mouse, Rat
Canine, Equine, Gallus, Human, Porcine, Rabbit
Rabbit
Polyclonal
Unconjugated
50 μl, 100 μl, 200 μl - MATR3 Antibody [orb1786056]
ELISA, FC, ICC, IF, IHC, WB
Human, Mouse, Rat
Rabbit
Polyclonal
Unconjugated
100 μg - Featured

ICC, IF, IHC-Fr, IHC-P, WB
Human, Mouse, Rat
Mouse, Rat
Rabbit
Recombinant
Unconjugated
50 μl, 100 μl - Featured

FC, ICC, IF, IHC-Fr, IHC-P, WB
Human, Mouse, Rat
Canine, Rabbit, Rat
Rabbit
Recombinant
Unconjugated
50 μl, 100 μl - Featured

IF, IHC-Fr, IHC-P
Human, Mouse, Rat
Mouse, Rat
Rabbit
Recombinant
Unconjugated
25 μl, 100 μl, 50 μl